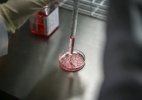

Método facilita escolha de gênero de bebês, mas queremos mesmo isso?
by
admin
01/01/1970
Tecnologia
Uma recente pesquisa realizada na Universidade de Hiroshima, no Japão, descobriu que alguns compostos químicos são capazes de retardar o esperma portador do cromossomo X (feminino) em relação ao Y (masculino). Desta maneira, tal experimento poderia, em última hipótese, conter o nascimento de meninas no mundo. Mas será que isso é necessário ou pode criar uma distopia sexista à la “Handmaid’s Tale”?
Uma recente pesquisa realizada na Universidade de Hiroshima, no Japão, descobriu que alguns compostos químicos são capazes de retardar o esperma portador do cromossomo X (feminino) em relação ao Y (masculino). Desta maneira, tal experimento poderia, em última hipótese, conter o nascimento de meninas no mundo. Mas será que isso é necessário ou pode criar uma distopia sexista à la “Handmaid’s Tale”?
Origem: Uol Tecnologia
